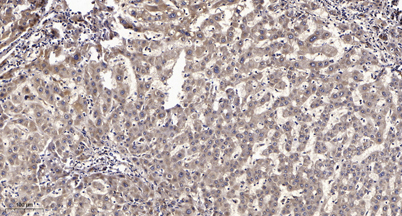

$148.00/50µL $248.00/100µL
| 50 µL | $148.00 |
| 100 µL | $248.00 |
| Product name: | RGS12 rabbit pAb |
| Reactivity: | Human;Mouse;Rat |
| Alternative Names: | RGS12; Regulator of G-protein signaling 12; RGS12 |
| Source: | Rabbit |
| Dilutions: | WB 1:500-2000;IHC-p 1:50-300; ELISA 2000-20000 |
| Immunogen: | The antiserum was produced against synthesized peptide derived from human RGS12. AA range:141-190 |
| Storage: | -20°C/1 year |
| Clonality: | Polyclonal |
| Isotype: | IgG |
| Concentration: | 1 mg/ml |
| Observed Band: | 160kD |
| GeneID: | 6002 |
| Human Swiss-Prot No: | O14924 |
| Cellular localization: | Nucleus . Cytoplasm . Cell projection, dendrite . Cell junction, synapse .; [Isoform 5]: Nucleus matrix . Also localized to discrete nuclear foci that are distinct from sites of RNA processing, PML nuclear bodies, and PcG domains. . |
| Background: | This gene encodes a member of the 'regulator of G protein signaling' (RGS) gene family. The encoded protein may function as a guanosine triphosphatase (GTPase)-activating protein as well as a transcriptional repressor. This protein may play a role in tumorigenesis. Multiple transcript variants encoding distinct isoforms have been identified for this gene. Other alternative splice variants have been described but their biological nature has not been determined. [provided by RefSeq, Jul 2008], |